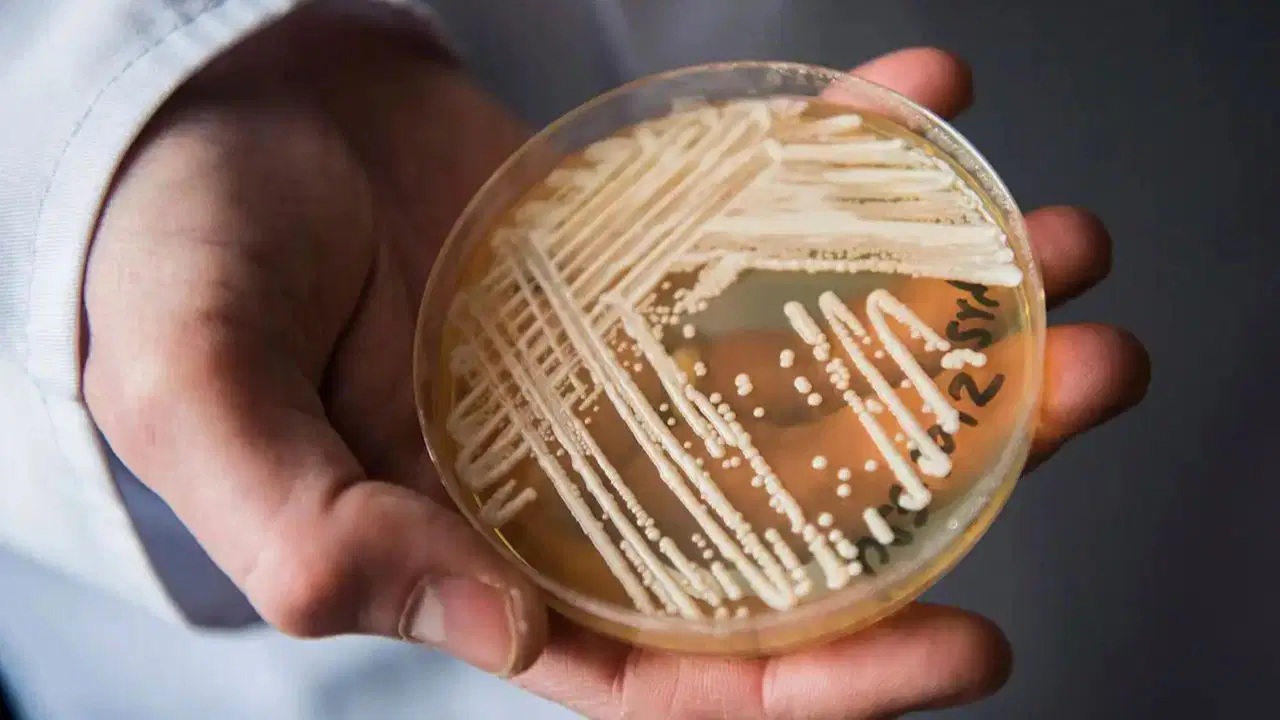
İlaçlara dirençli ölümcül mantar dünyaya yayılıyor

Havayolu ulaşımında zirve... İstanbul ve Sabiha Gökçen rekor kırdı
 2 saat önce
12
2 saat önce
12
İstanbul ve Sabiha Gökçen havalimanlarında 2025 yılında gerçekleşen iç ve dış hat seferleriyle taşınan yolcu sayısı, tüm zamanların en yüksek seviyesine ulaştı.
İlgili
MİT'ten Nokta Operasyonlar!
Şu anda
0
Köprü ve otoyol ücretlerinde değişiklik! Bakan Uraloğlu: Vat...
1 dakika önce
0
2026'da iş hayatı değişecek 7 burç: Koç, İkizler, Başak, Boğ...
1 dakika önce
0
TÜRGEV Yönetim Kurulu Başkanı Hatice Akıncı Yılmaz: Filistin...
2 dakika önce
0
İlaçlara dirençli ölümcül mantar dünyaya yayılıyor
3 dakika önce
0
Kar fındıkta soğuklama sürecine katkı sağladı
8 dakika önce
0
Darbukadan süpürgeye, Playstation'dan bisiklete... İstanbul'...
8 dakika önce
0
Erkek arkadaşı gözaltında, ekipler Balıkesir’de seferber: El...
10 dakika önce
0
Ertesi gün sendromuna son: Yılbaşı yorgunluğunu ve ödemini a...
10 dakika önce
0
Avrupa’nın en tehlikeli şehirleri belli oldu
14 dakika önce
0
Trend olanlar
Popüler
BM’den Korkutan Rapor: 1,5 Derece Eşiği Çok Yaklaştı!
1 ay önce
1516
ABD'de 'listeria' alarmı! 6 kişi öldü, salgın paniği...
1 ay önce
1482
BM Genel Sekreteri Guterres'ten Sudan uyarısı
1 ay önce
1471
© sozcu.tv.tr 2025. Tüm hakları saklıdır
.png)